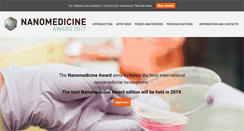
Desktop Preview

nanomedicina.hu
nanomedicina.hu
Index of /
Fullerene, CNTs, Graphene. We are well aware that the European Commission’s Framework Programmes support and encourage research and development in nanotechnology, especially in the fields related to environment, health and safety (nanoEHS) issues (see. Http:/ www.observatorynano.eu/. On Emerging and Newly Identified Health Risks (SCENIHR) recently. Published an opinion on developments in the risk assessment of nanomaterials (NMs). The opinion, built on and confirming earlier documents indicates that ...
 nanomedicina77.blogspot.com
nanomedicina77.blogspot.com
NANOMEDICINA
Este articulo describe brevemente como se utiliza la NANOTECNOLOGIA en la MEDICINA. La nanotecnología desempeña un papel muy importante en el desarrollo. De diagnóstico de enfermedades y nuevas terapias contra enfermedades de la médula espinal, Parkinson, Alzheimer. El uso de la nanotecnología en la terapia celular ofrece prometedoras perspectivas de futuro para el cerebro, y el tratamiento de la lesión medular. Domingo, 5 de diciembre de 2010. NANOTECNOLOGÍA Y EL ALZHEIMER. Enviar por correo electrónico.
 nanomedicinafisica.wordpress.com
nanomedicinafisica.wordpress.com
nanomedicinafisica | Just another WordPress.com site
Just another WordPress.com site. Permanece al día vía RSS. Parques Nacionales en Red. La ciencia también se equivoca. Año de la química. Lo que no ves. Publicado: junio 12, 2011 en Uncategorized. Queridos blogueros, blogueras, gente que nos ha seguido, amigos y familiares nuestro blog de la Nanomedicina se despide; esperamos que os haya gustado. Y… recordad que: la nanomedicina es un extenso campo que se está extendiendo! Una visión del futuro que se está haciendo verdad. Acabar con las células cancerosas.
 nanomedicinas.com
nanomedicinas.com
Home - Nanomedicinas
Plataforma de investigación y desarrollos Nanotecnológicos. Es una de las vertientes más prometedoras dentro del campo de la medicina y representa, de manera muy especial, la principal vía tecnológica para la curación de enfermedades desde el interior del propio cuerpo, a nivel celular o molecular.
 nanomedicinas.unq.edu.ar
nanomedicinas.unq.edu.ar
PROGAMA de NANOMEDICINAS
PhD thesis and undergraduate thesis. Therapeutic, prophylactic and theranostic nanomedicines. Therapeutic strategies and nanovaccination against parasites and bacteria. Therapeutic strategies against inflammatory noncommunicable diseases affecting the lungs, cardio vasculature and gastrointestinal tract. Nanomedicines designed for mucosal (oral and respiratory) and topical routes. Nanomedicine Research and Development Center (NaRDC) - Quilmes National University.
 nanomedicine-award.com
nanomedicine-award.com
Nanomedicine Award 2017 – Nanomedicine Award 2017
Aims to honor the best international nanomedicine innovations. The next Nanomedicine Award edition will be held in 2019. Aims to honor the best international nanomedicine innovations with two categories:. Most Promising Nanomedicine Project. Best Nanomedicine Product / Deal,. It is open to companies, academic and private researchers from Europe and beyond. The winners of the Nanomedicine Award 2017 are:. LIFNano Therapeutics (United Kingdom). Find the Press Release.
 nanomedicine-day.com
nanomedicine-day.com
Welcome nanomedicine-day.com - BlueHost.com
Web Hosting - courtesy of www.bluehost.com.
 nanomedicine-explorer.net
nanomedicine-explorer.net
Home | Nanomedicine Explorer
To this virtual exhibit. Hear stories from researchers. Working on the cutting edge of. 2008-2013 Museum of Science, Boston. 2008 Museum of Science, Boston.
 nanomedicine-jpn.org
nanomedicine-jpn.org
日本ナノメディシン交流協会
11th International Symposium on Nanomedicine ( ISNM2017.
 nanomedicine-rj.com
nanomedicine-rj.com
Nanomedicine Research Journal
Nanomedicine Research Journal (NMRJ). Nanomedicine Research Journal ( Abbreviation: Nanomed Res J. Publication process of manuscripts submitted to Nanomed Res J is free of charge. To see Acceptance timeline Please follow the link below:. Founded in 2011 by the leading of. School of Advanced Technologies in medicine (SATiM),. Tehran University of Medical Sciences (TUMS). Iran Nanotechnology Initiative Council. Pluronic based nano-delivery systems; Prospective warrior in war against cancer. Hadi Baharifar;...
 nanomedicine.asia
nanomedicine.asia
Test Page for the Nginx HTTP Server on Fedora
This page is used to test the proper operation of the nginx. HTTP server after it has been installed. If you can read this page, it means that the web server installed at this site is working properly. This is the default. Page that is distributed with nginx. On Fedora. It is located in. You should now put your content in a location of your choice and edit the. Configuration directive in the nginx.